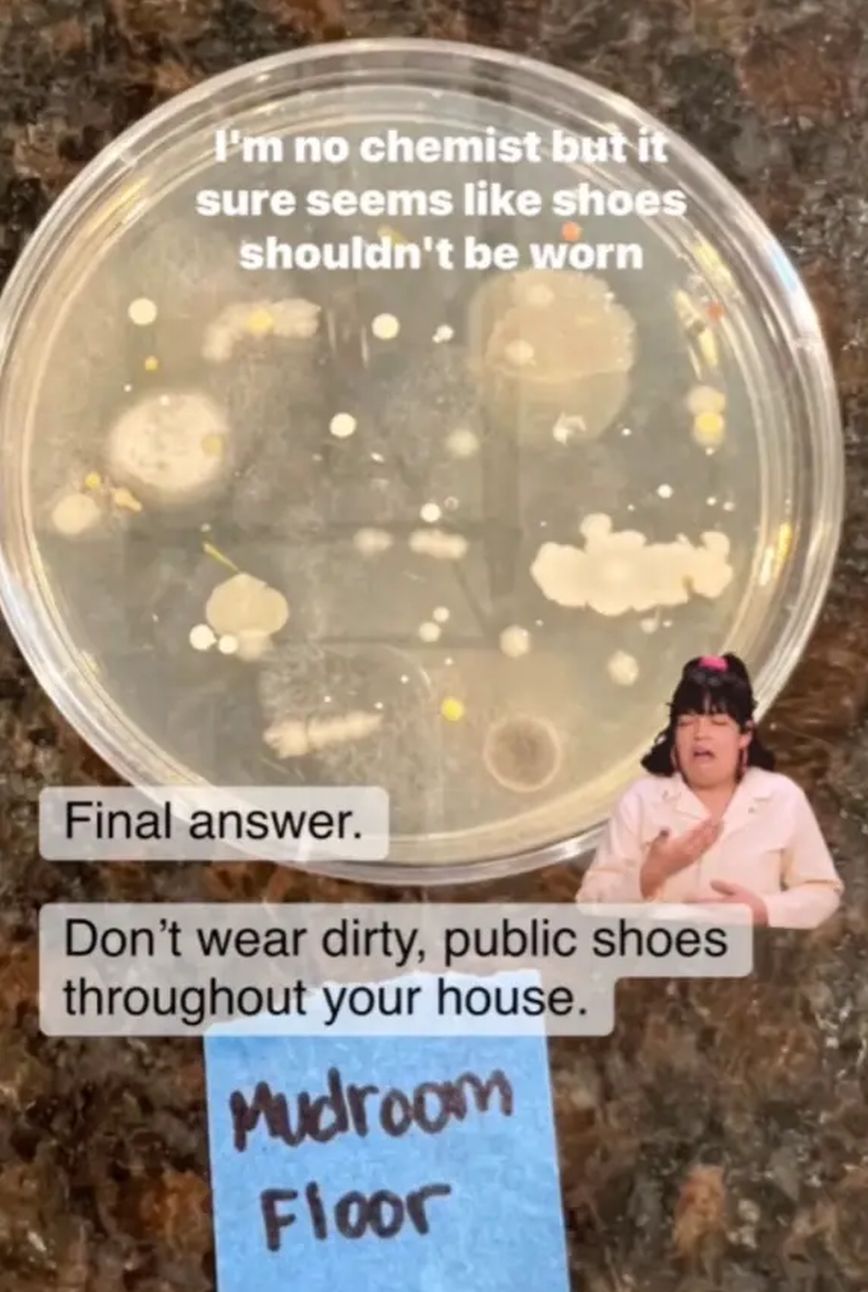

Το να φοράτε παπούτσια σε εσωτερικούς χώρους σημαίνει πως βάζετε μια πληθώρα μικροβίων στο σπίτι σας. Αν και δεν είναι μυστικό ότι τα δημόσια πεζοδρόμια, τα πάρκα και τα δάπεδα γεμίζουν με βακτήρια, το πείραμα ενός δημιουργού περιεχομένου αποκάλυψε την αποκρουστική αλήθεια για τα όσα έχουν υπάρχουν στο κάτω μέρος των παπουτσιών σας.
Η Dena O’Neill, μια «γκουρού» στον καθαρισμό και την οργάνωση του σπιτιού που έχει περισσότερους από 33.000 ακολούθους στο Instagram, μοιράστηκε την άθλια πραγματικότητα του να φοράει κάποιος παπούτσια σε εσωτερικούς χώρους αφού σκούπισε το κάτω μέρος των υποδημάτων της.
Σε ένα Instagram Reel που έχει συγκεντρώσει περισσότερα από 20.000 likes, η O’Neill ξεκίνησε ένα πείραμα για να διευθετήσει τη συζήτηση μεταξύ των υποστηρικτών και των σκεπτικιστών της χρήσης παπουτσιών σε εσωτερικούς χώρους.
«Πριν από μερικές εβδομάδες, έκανα μια δημοσκόπηση ρωτώντας ποιος φοράει παπούτσια που χρησιμοποιεί όταν βγαίνει έξω, στο σπίτι του», έγραψε στη λεζάντα. «Έμεινα έκπληκτη με το πόσοι άνθρωποι είπαν ΝΑΙ» ανέφερε αρχικά η O’Neill. Υπάρχουν περισσότερα περιττώματα στα πεζοδρόμια από όσο νομίζετε. Τα βακτήρια από τα περιττώματα στα πεζοδρόμια είναι παντού στο σπίτι σας, σύμφωνα με μελέτη, υποστήριξε η γυναίκα και συνέχισε: «Έτσι, ήθελα να καταλάβω πόσο βρώμικα είναι τα φορεμένα δημόσια παπούτσια μας ΚΑΙ το πάτωμα όπου περπατάμε με αυτά τα παπούτσια».
Περπάτησε με τα παπούτσια της στην είσοδο του σπιτιού της, και αφού έβαλε τα παθογόνα που βρισκόταν κάτω από τα παπούτσια με μπατονέτα σε ένα τρυβλίο τα άφησε να μαυρίσουν για μια εβδομάδα σε μια σκοτεινή ντουλάπα, μεταδίδει η New York Post.
Το αποτέλεσμα ήταν πως ένας αριθμός βακτηρίων ανθούσε και στα δύο ειδικά πλαστικά πιάτα που είχαν «ταρακουνήσει» την O’Neill. Ενώ παραδέχτηκε ότι δεν ήξερε «τι ακριβώς αναπτύσσεται σε αυτά τα πιάτα», είπε ότι πιθανώς «δεν είναι καλά βακτήρια» λόγω των πολλών ακάθαρτων σημείων που ταξιδεύουν τα παπούτσια μας σε εξωτερικούς χώρους, όπως πάρκα και γρασίδι όπου «ζώα ουρούν και κάνουν κακά, δημόσιες τουαλέτες και κοινόχρηστοι όροφοι όπου άλλοι περπατούν με τα υπαίθρια παπούτσια τους. «Λοιπόν πριν από αυτό το πιάτο Petri, δεν φορούσαμε παπούτσια στο σπίτι, και μετά το πιάτο Petri, επιμένω στην απόφασή μου», κατέληξε.
«Αν φοράς αυτά τα παπούτσια μέσα στο σπίτι σου, πρέπει να καθαρίζεις τα πατώματα σου ΠΟΛΥ ΣΥΧΝΑ. Αυτό διαρκεί πολύ περισσότερο από το να βγάλεις τα παπούτσια», είπε, συμβουλεύοντας τους θεατές να αγοράσουν ένα ζευγάρι slip-on για χρήση μόνο σε εσωτερικούς χώρους.
Μια μελέτη από το Marymount Manhattan College φέτος διαπίστωσε ότι τα βακτήρια παρέμειναν ακόμη και μετά την απομάκρυνση των περιττωμάτων, δήλωσε στην The Post ένας από τους συν-συγγραφείς της μελέτης. «Βρήκαμε αριθμούς βακτηρίων που ήταν απολύτως εκπληκτικοί», είπε η καθηγήτρια χημείας Alessandra Leri.